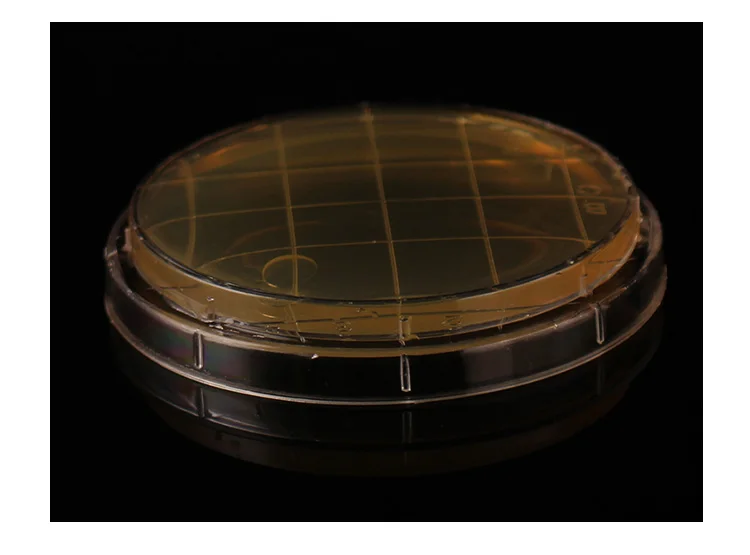
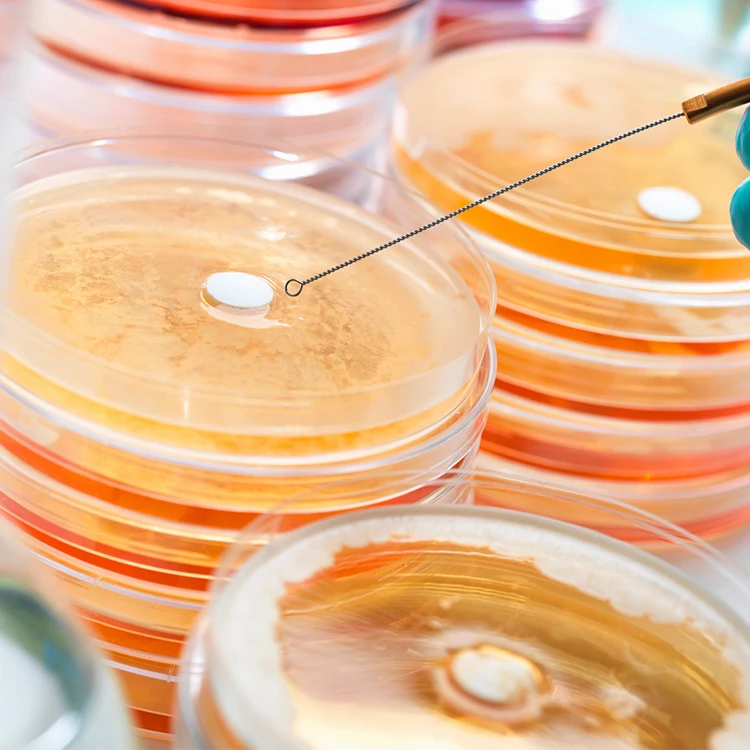
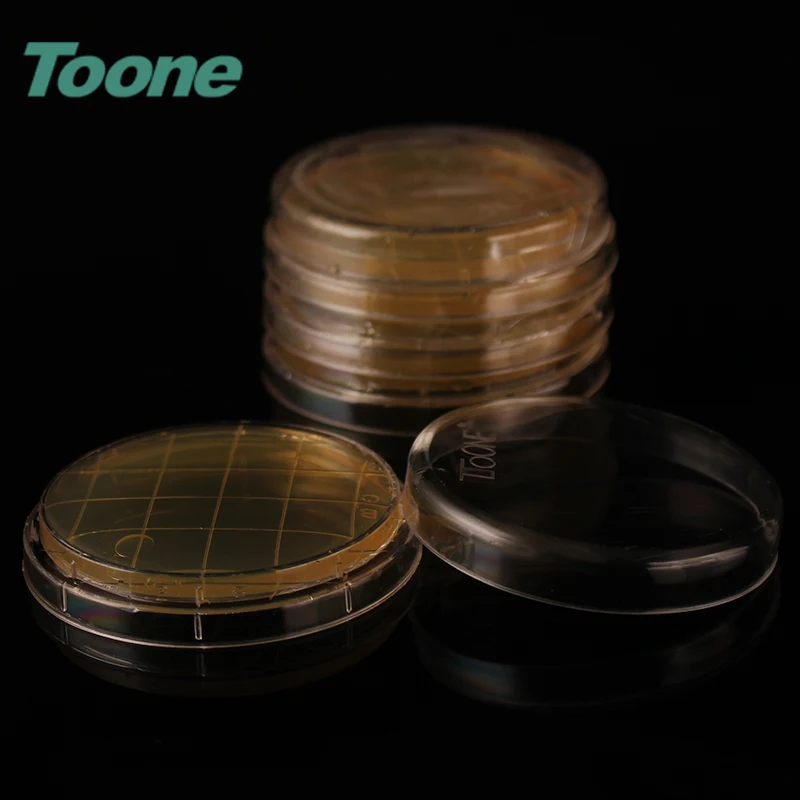
TOONE TW-55CY  55mm Plastic Pre-filled Sterile Bacterial Tissue Culture Petri Dish with Lid Lab Accessories

TOONE TW 55CY 55mm Plastic Pre filled Sterile Bacterial Tissue Culture Petri Dish with Lid Lab Accessories
- Category: Testing Equipment >>>
- Supplier: Wenzhou Tuwang Biotechnology Equipment Co. Ltd.
Share on (1600222866487):
Product Overview
Description
Different sizes can be choosed
Product No. | Product Name | TW-90CY Specification | TW-75CY Specification | TW-55CY Specification |
7001 | Tryptic Soy Agar Medium (TSA) | TW-90CYTSA | TW-75CYTSA | TW-55CYTSA |
7002 | Tryptic Soy Agar Medium (containing penicillinase) | TW-Q90CYTSA | TW-Q75CYTSA | TW-Q55CYTSA |
7003 | Tryptic Soy Agar Medium (containing cephalosporinase) | TW-T90CYTSA | TW-T75CYTSA | TW-T55CYTSA |
7004 | Plate Count Agar (PCA) | TW-90CYPCA | TW-75CYPCA | TW-55CYPCA |
7005 | Sabouraud Dextrose Agar Medium (SDA) | TW-90CYSDA | TW-75CYSDA | TW-55CYSDA |
7006 | Sabouraud Dextrose Agar Medium (containing chloramphenicol) | TW-L90CYSDA | TW-L75CYSDA | TW-L55CYSDA |
7007 | Rose Bengal Agar Medium (RA) | TW-90CYRA | TW-75CYRA | TW-55CYRA |
7008 | Rose Bengal Medium | TW-90CYMJL | TW-75CYMJL | TW-55CYMJL |
7009 | R2A Agar Medium | TW-90CYR2A | TW-75CYR2A | TW-55CYR2A |
7010 | Xylose Lysine Desoxycholate (XLD) Agar Medium | TW-90CYXLD | TW-75CYXLD | TW-55CYXLD |
7011 | Violet Red Bile Glucose Agar Medium (VRBGA) | TW-90CYVRBGA | TW-75CYVRBGA | TW-55CYVRBGA |
7012 | MacConkey (MAC) Agar | TW-90CYMAC | TW-75CYMAC | TW-55CYMAC |
7013 | Cetrimide Agar Medium (CA) | TW-90CYCA | TW-75CYCA | TW-55CYCA |
7014 | Mannitol and Sodium Chloride Agar Medium (MSA) | TW-90CYMSA | TW-75CYMSA | TW-55CYMSA |
7015 | Columbia Agar Medium | TW-90CYGLBY | TW-75CYGLBY | TW-55CYGLBY |
7016 | Candida Chromogenic Medium | TW-90CYNZ | TW75-CYNZ | TW55-CYNZ |
7017 | SS Agar | TW-90CYSS | TW-75CYSS | TW-55CYSS |
7018 | Violet Red Bile Agar (VRBA) | TW-90CYVRBA | TW-75CYVRBA | TW-55CYVRBA |
7019 | Violet Red Bile Dextrose Agar/Violet Red Bile Glucose Agar (VRBDA/VRBGA) | TW-90CYVRBDA | TW-75CYVRBDA | TW-55CYVRBDA |
7020 | Nutrient Agar | TW-90CYNA | TW-75CYNA | TW-55CYNA |
7021 | Hektoen Enteric Agar (HE) | TW-90CYHE | TW-75CYHE | TW-55CYHE |
7022 | Mannitol-Egg-Yolk-Polymyxin (MYP) Agar | TW-90CYMYP | TW-75CYMYP | TW-55CYMYP |
7023 | Enterobacter Sakazakii Chromogenic Medium | TW-90CYBQC | TW-75CYBQC | TW-55CYBQC |
7024 | Basal Layer Medium | TW-90CYDC | TW-75CYDC | TW-55CYDC |
7025 | TrypticSoy Agar Medium (containing Tween 80 and lecithin) | TW-90CYTSA80R | TW-75CYTSA80R | TW-55CYTSA80R |
7026 | Sabouraud Dextrose Agar Medium (containing gentamicin) | TW-Q90CYSDA | TW-Q75CYSDA | TW-Q55CYSDA |
Product Description
Specification:
-Optically clear Petri Dishes made from Heavy Duty Food Grade Polystyrene plastic. Ethylene oxide sterilization, unvented, with lids,and have smooth surface and optimal transparent body.
- Optimized Design for Growing Bacteria - Perfectly sized 55mm dishes with triple vented lids allow an optimal airflow for cultivation of nutrient agar and to grow bacteria, mold, yeast, fungus and other microbes and organisms.
- Packing information - Sealed and dustproof plastic bag packaging to prevent pollution and effectively protect the optical surface of the culture dish.
- Optimized Design for Growing Bacteria - Perfectly sized 55mm dishes with triple vented lids allow an optimal airflow for cultivation of nutrient agar and to grow bacteria, mold, yeast, fungus and other microbes and organisms.
- Packing information - Sealed and dustproof plastic bag packaging to prevent pollution and effectively protect the optical surface of the culture dish.
Product advantages:
1)Material: Made of high grade PC material
2)Size:55mmx15mm
3)Chemical corrosion and low temperature resistance
4)Packing:10 sets/bag,50 bags/CTN
2)Size:55mmx15mm
3)Chemical corrosion and low temperature resistance
4)Packing:10 sets/bag,50 bags/CTN
Detailed Images
Dish design
(Transparent and well matched )
Dish body design
(Thickened plastic not easy to break)

Edge design
(Transparent and smooth,convenient to use)

Certificate



Company Introduction
Wenzhou tuwang biotechnology co., LTD. is a science and technology enterprise in zhejiang province, the domestic excellent microorganism detection related equipment, instruments and consumables Manufacturer, for biopharmaceutical engineering to provide Sterile transfer cabin, hydrogen peroxide sterilizer, Aseptic isolator, and Comprehensive service providers such as installation and commissioning, testing and verification, training and after-sales service.
Tuwang has always insisted on innovation-driven development. It is one of the earliest manufacturers in China to develop a fully enclosed membrane filtration sterile testing device, vaporized hydrogen peroxide sterilization system, sterile isolation system, environmental control detection equipment and consumables, and has achieved multiple An enterprise that automates the production of products. Has many new patents: the negative pressure safety cabin successfully applied the protective production of highly active drugs.
Aseptic isolator, VHP vaporized hydrogen peroxide sterilizer, glove leak detector, negative pressure biological safety chamber, smart homogenizer, Microbial limit incubator, Sterility test kits , Culture dish, collection of bacteria, and limit of microorganisms A series of high-tech products such as inspection systems, bacterial culture dishes, repeated use incubators, open incubators, microporous membranes, penicillin mold, cephalosporin mold, etc., have been fully accepted by the market. The company focuses on technological innovation and has a wide range of products It is used in many fields such as the detection of drugs and biological products, disease prevention and control, environmental protection, and food and cosmetics detection. The technology and methods of the company's many products have been included in the "Chinese Pharmacopoeia", and the products can cover all levels of food and drug inspection institutes, major pharmaceutical companies, drug research institutions and other enterprises and institutions across the country.
Tuwang has always insisted on innovation-driven development. It is one of the earliest manufacturers in China to develop a fully enclosed membrane filtration sterile testing device, vaporized hydrogen peroxide sterilization system, sterile isolation system, environmental control detection equipment and consumables, and has achieved multiple An enterprise that automates the production of products. Has many new patents: the negative pressure safety cabin successfully applied the protective production of highly active drugs.
Aseptic isolator, VHP vaporized hydrogen peroxide sterilizer, glove leak detector, negative pressure biological safety chamber, smart homogenizer, Microbial limit incubator, Sterility test kits , Culture dish, collection of bacteria, and limit of microorganisms A series of high-tech products such as inspection systems, bacterial culture dishes, repeated use incubators, open incubators, microporous membranes, penicillin mold, cephalosporin mold, etc., have been fully accepted by the market. The company focuses on technological innovation and has a wide range of products It is used in many fields such as the detection of drugs and biological products, disease prevention and control, environmental protection, and food and cosmetics detection. The technology and methods of the company's many products have been included in the "Chinese Pharmacopoeia", and the products can cover all levels of food and drug inspection institutes, major pharmaceutical companies, drug research institutions and other enterprises and institutions across the country.
Adhere to the "quality, cast brand" business philosophy.In the field of asepsis and microbiology deep roots, while doing a good job in the new and old product renewal the work of the replacement.Tuwang company constantly with rich products and quality service to meet the growing market demand.



Packing&Shipping


FAQ
Q:Can you produce the product as our sample?
A:Yes,we can.As long as you give us the detailed specific requirement, or better send us original sample,we can absolutely make the same sample and send to you for approval.
Q: Are you a manufacuturer or a trading company?
A: We are a manufacuturer and exporter.
Q:Can we use our own shipping agent?
A: Sure!
Q:Can we use our own logo for packing?
A:YES , OEM is acceptable,please send email to u for more details
Q:Where is your factory?
A:Yes,we can.As long as you give us the detailed specific requirement, or better send us original sample,we can absolutely make the same sample and send to you for approval.
Q: Are you a manufacuturer or a trading company?
A: We are a manufacuturer and exporter.
Q:Can we use our own shipping agent?
A: Sure!
Q:Can we use our own logo for packing?
A:YES , OEM is acceptable,please send email to u for more details
Q:Where is your factory?
A:Our company is located in Wenzhou, very close to Ningbo Port and Shanghai Port.
Q:What is the shelf life of the product?
A:2 years
Q:How long is the delivery time?
A:We have most of them in stock , unless special circumstances if the customer volume, we need a month to arrange production.
Buying Guides
Buyer Reading
1) Please be noted that the price in our website is merely the reference price and the actual one is subject to our final confirmation!
2) Any problem, requirement and suggestion, please contact us freely, we'd be very pleased to be at your side.
Before Sale Service
Before Sale Service
1. Your inquiry will be reply in 24 hours.
2. We will provide you with newest quotation and the specific product specifications.
3. Good quality product, quick delivery time, competitive price, strong packing
4. We have good
translations, enthusiastic sales and service who can speak fluently in English
translations, enthusiastic sales and service who can speak fluently in English
5. We offer OEM services. Can print your logo on
product, can customize the packing and other things.
product, can customize the packing and other things.
6. Our engineers have R&D experiences and have strong ability to do ODM
projects.
projects.
7. Every product will be checked well in order to ensure the high quality.
8. Provide detailed products test report.
After Sale service
After Sale service
1. Updated the shipping information as soon as possible.
2. Ensure delivery on time. 3. Documents will be send
correctly and promptly.
Privacy Policy
correctly and promptly.
Privacy Policy
We are professional apparatus products manufacturing company and we respect our customers and their privacy, which
is why all the information we get from our customers is confidentially kept and not given to any other third party. We ask for certain information from our customers to process our orders and to help us provide them with special offers, newsletters and better Customer Service.
is why all the information we get from our customers is confidentially kept and not given to any other third party. We ask for certain information from our customers to process our orders and to help us provide them with special offers, newsletters and better Customer Service.
We Recommend
New Arrivals
New products from manufacturers at wholesale prices